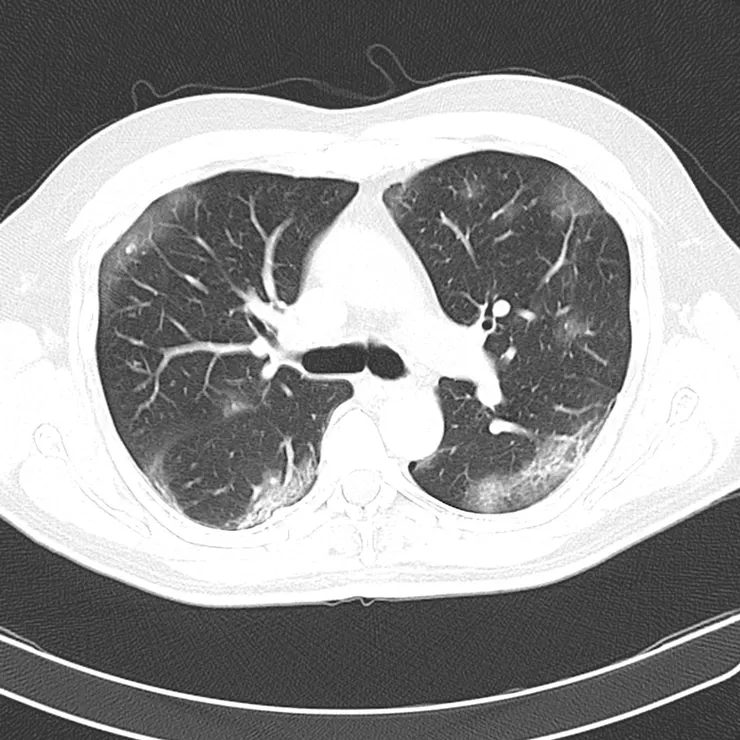
vocus｜新世代的創作平台

不要告訴我,無症狀感染者,肺都是健康的,人也是不會死的。

在國外的研究,
1.篩查測試的【偽陰性率】,可以高達【20%】(錯誤地告訴人們,你沒有感染的機率)
2.更多達【40-45%】的SARS-CoV-2感染者,是保持無症狀,但其病毒承載量,與那些確診病例,病毒活躍量是相同。
(Asymptomatic persons seem to account for approximately 40% to 45% of SARS-CoV-2 infections, and they can transmit the virus to others for an extended period, perhaps longer than 14 days.)
這些無症狀感染者病毒🦠量的傳播能力,可以達到14天,「什至超過14天」。
但更諷刺的是,在國外會告知這些人,有症狀才就診,問題是他們是無症狀感染者呀!或叫他們量體溫🤒️,但是他們就是不會發燒🤒️啊!而身體上的病毒🦠量和確診病例一模一樣的。
不要以為,這些無症狀感染者,沒有症狀出現,不代表肺的器官是正常的。這些有太多研究...
那些無症狀者,但檢查呈陽性率

無症狀感染者,他們的「病毒🦠量和確診病例的病毒🦠量是一樣多」的。
他們佔了所有COVID 19的40%以上,而這些無症狀感染者,其《核酸檢測陽性率》,幾乎都是【50%以上】的,千萬不要以為無症狀,病毒能量低,才造成這些人無症狀。
“無症狀”感染者 (Asymptomatic) 和 “症狀前”感染者(Pre-Symptomatic),兩組不同
一般民眾和媒體都廣泛使用“無症狀”一詞統稱,來描述兩組不同的COVID-19患者-
“無症狀”感染者 (Asymptomatic) 和 “症狀前”感染者(Pre-Symptomatic)
兩者之間,其實仍有所不同。
“無症狀”感染者 (Asymptomatic) : 是指一個人沒有症狀但感染了病毒 。
“症狀前”感染者(Pre-Symptomatic) : 是指一個人被感染且可能正在散發病毒但尚未出現症狀的階段。
基本上,對於沒有症狀但暴露於COVID-19的人,PCR測試可以顯示他們是否患有病毒 :
PCR測試陽性(+) 測試後,人後來才出現症狀,這是確診後出現的症狀者(pre-symptomatic)、也叫“症狀前”感染者(Pre-Symptomatic)
PCR測試陽性(+) 測試後,人從不出現症狀,則才叫“無症狀”感染者 (Asymptomatic) 。
無症狀感染者,也會變成有症狀者
這是確診後出現症狀者(pre-symptomatic)、也叫“症狀前”感染者(Pre-Symptomatic)
在希臘和紐約的研究中,一般“症狀前”感染者(Pre-Symptomatic) 民眾者中,最終有【10.3%】左右會有症狀出現。

但在長照機構的住民 最初無症狀的27位住民中,有24位【88.9%】最終出現症狀。這些人,可能年齡大,合併多慢性病,症狀出現也特別容易,無症狀感染者,機率很高,但是演變成有症狀感染者的機率,也很高的。
在美國軍艦羅斯福號上,有近【60%以上】都是無症狀感染者,且有些過了14天,篩檢依舊是陽性。專家認為年輕人(20-30歲),容易出現無症狀感染,且可以超過14天後,仍然呈現病毒陽性🦠。
年紀大,慢性病,愈容易出現症狀。年輕人的無症狀感染,可以超過14天後,仍然呈現病毒陽性,即使當時也是無症狀的。
無症狀感染者,肺依舊被破壞
「無症狀,不是等於身體無傷害。」
愈來愈多,科學研究證明,這些無症狀感染者,他們的肺部仍然持續受到很大的損害。
武漢研究

來自中國武漢的一項研究描述58位完全無症狀患者的CT掃描顯示 : 主要位於肺的外周(44%) 和肋膜下區域(75.9%),主要在一個 (38%) 或兩個肺葉(65.5%)。 肺部混濁是朦朧的白色雲層(CGO) 病變傾向於分佈在下葉(左62.1%, 右 68.9%)。而且58位完全無症狀患者,【94.8%】的CT掃描是有明顯病變。
鑽石公主號
研究人員觀察了鑽石公主號遊輪上乘客的CT掃描。在沒有咳嗽或發燒等症狀的76人中,有【54%】的人表現出明顯的肺部異常
特別是肺部浸潤。肺部浸潤似毛玻璃現象,形成了朦朧的白色薄雲層,與肺部的黑暗形成對比,這通常表明肺部充滿了發炎液體,來自細菌和免疫細胞戰爭後的成果。
無症狀感染者,依舊會死人 : 隱形缺氧(Silent Hypoxia)
幾乎在所有臨床經驗中,肺部發生疾患時,吸收氧及排除二氧化碳的能力也都會出問題,但COVID-19這種疾病卻不同。醫界先前就在高海拔【登山者】和【飛行員】身上觀察到有隱形缺氧(Silent Hypoxia)的現象 :

這是因為高度增加時,氣壓會隨之降低,所以每次吸氣獲得的氧分子較少,但急促呼吸時仍會排出二氧化碳。COVID-19患者的情況與飛行員有幾分類似,【無症狀感染者的病患】,在染疫初期大多仍保有良好的心臟功能,因此仍有能力將血液輸送到身體末梢部位。
COVID-19與其他呼吸道疾病不同,會慢慢讓身體缺氧,無症狀感染者病患初期,開始並不會讓人感到呼吸困難,但部分患者會逐漸覺得《難以呼吸》或《感到胸悶》;這兩者,都是美國疾病管制與預防中心列為緊急危險徵兆的症狀,出現時病情已經相當危急。

很多【無症狀感染者併隱形缺氧】(Silent Hypoxia),他們的症狀讓許多醫師大感驚訝,有些患者的血氧濃度低到,醫護人員原本認為他們應該已經語無倫次或處於休克狀態,但他們卻【意識清楚】、【情緒平穩】而且能【正常應答】,可以和醫師聊天,也【可以滑手機】。這些隱形缺氧是逐漸發生的,難以察覺,所以也被稱為隱形殺手。
隱形缺氧怎麽發生 ?
附著在細胞膜表面的受體蛋白「ACE2」上入侵細胞,而肺臟和肺泡上有非常多的ACE2。一旦病毒侵犯的細胞達到一定數量,人體免疫反應和病毒之間的大戰就會造成許多破壞。這可能會阻礙氧氣從肺泡進入血液的通道,但是二氧化碳可以較快從血液進入肺臟、排出體外,因此較不受影響。隱形缺氧發生時,就難以察覺,

COVID-19會使肺部的氧氣移動與血流不協調(V/Q mismatch)。一般來說,血管會收縮,讓血液盡量流入肺臟中充滿氣體的部位載運氧氣,減少缺氧部位的血流。但COVID-19患者的這套保衛機制可能會失常,使得更多血液流向肺臟受損的部位,反而較少血液流經健康部位。所以隱形缺氧,才是逐漸發生的,難以察覺。
一切來不及了
太多研究指著冠狀病毒,是可能會影響肺功能,儘管對患者來說,症狀可能還不是很明顯。國外很多的建議是鼓勵患者,在沒有症狀的情況下,呆在家裡(Stay Home),但到醫院就診時,又往往太遲了。

其實很多「病者本身,是自己根本沒有能力判斷自己是不是要去看醫生」的,一直吸不到氣,昏迷,臉色變黑....這些會造成很多在家突然死亡的病例,一直在上昇,死後才知道,原來這些都是COVID19 造成的,而一切,他這一生都來不及了。
來源:
https://www.acpjournals.org/doi/10.7326/M20-3012
如果你已經看到最後 : 【免費支持我】
幫我按下方的 [拍手五下],我有機會獲得內容創作的酬勞喔~
創作不易啊...參考來源 :




















